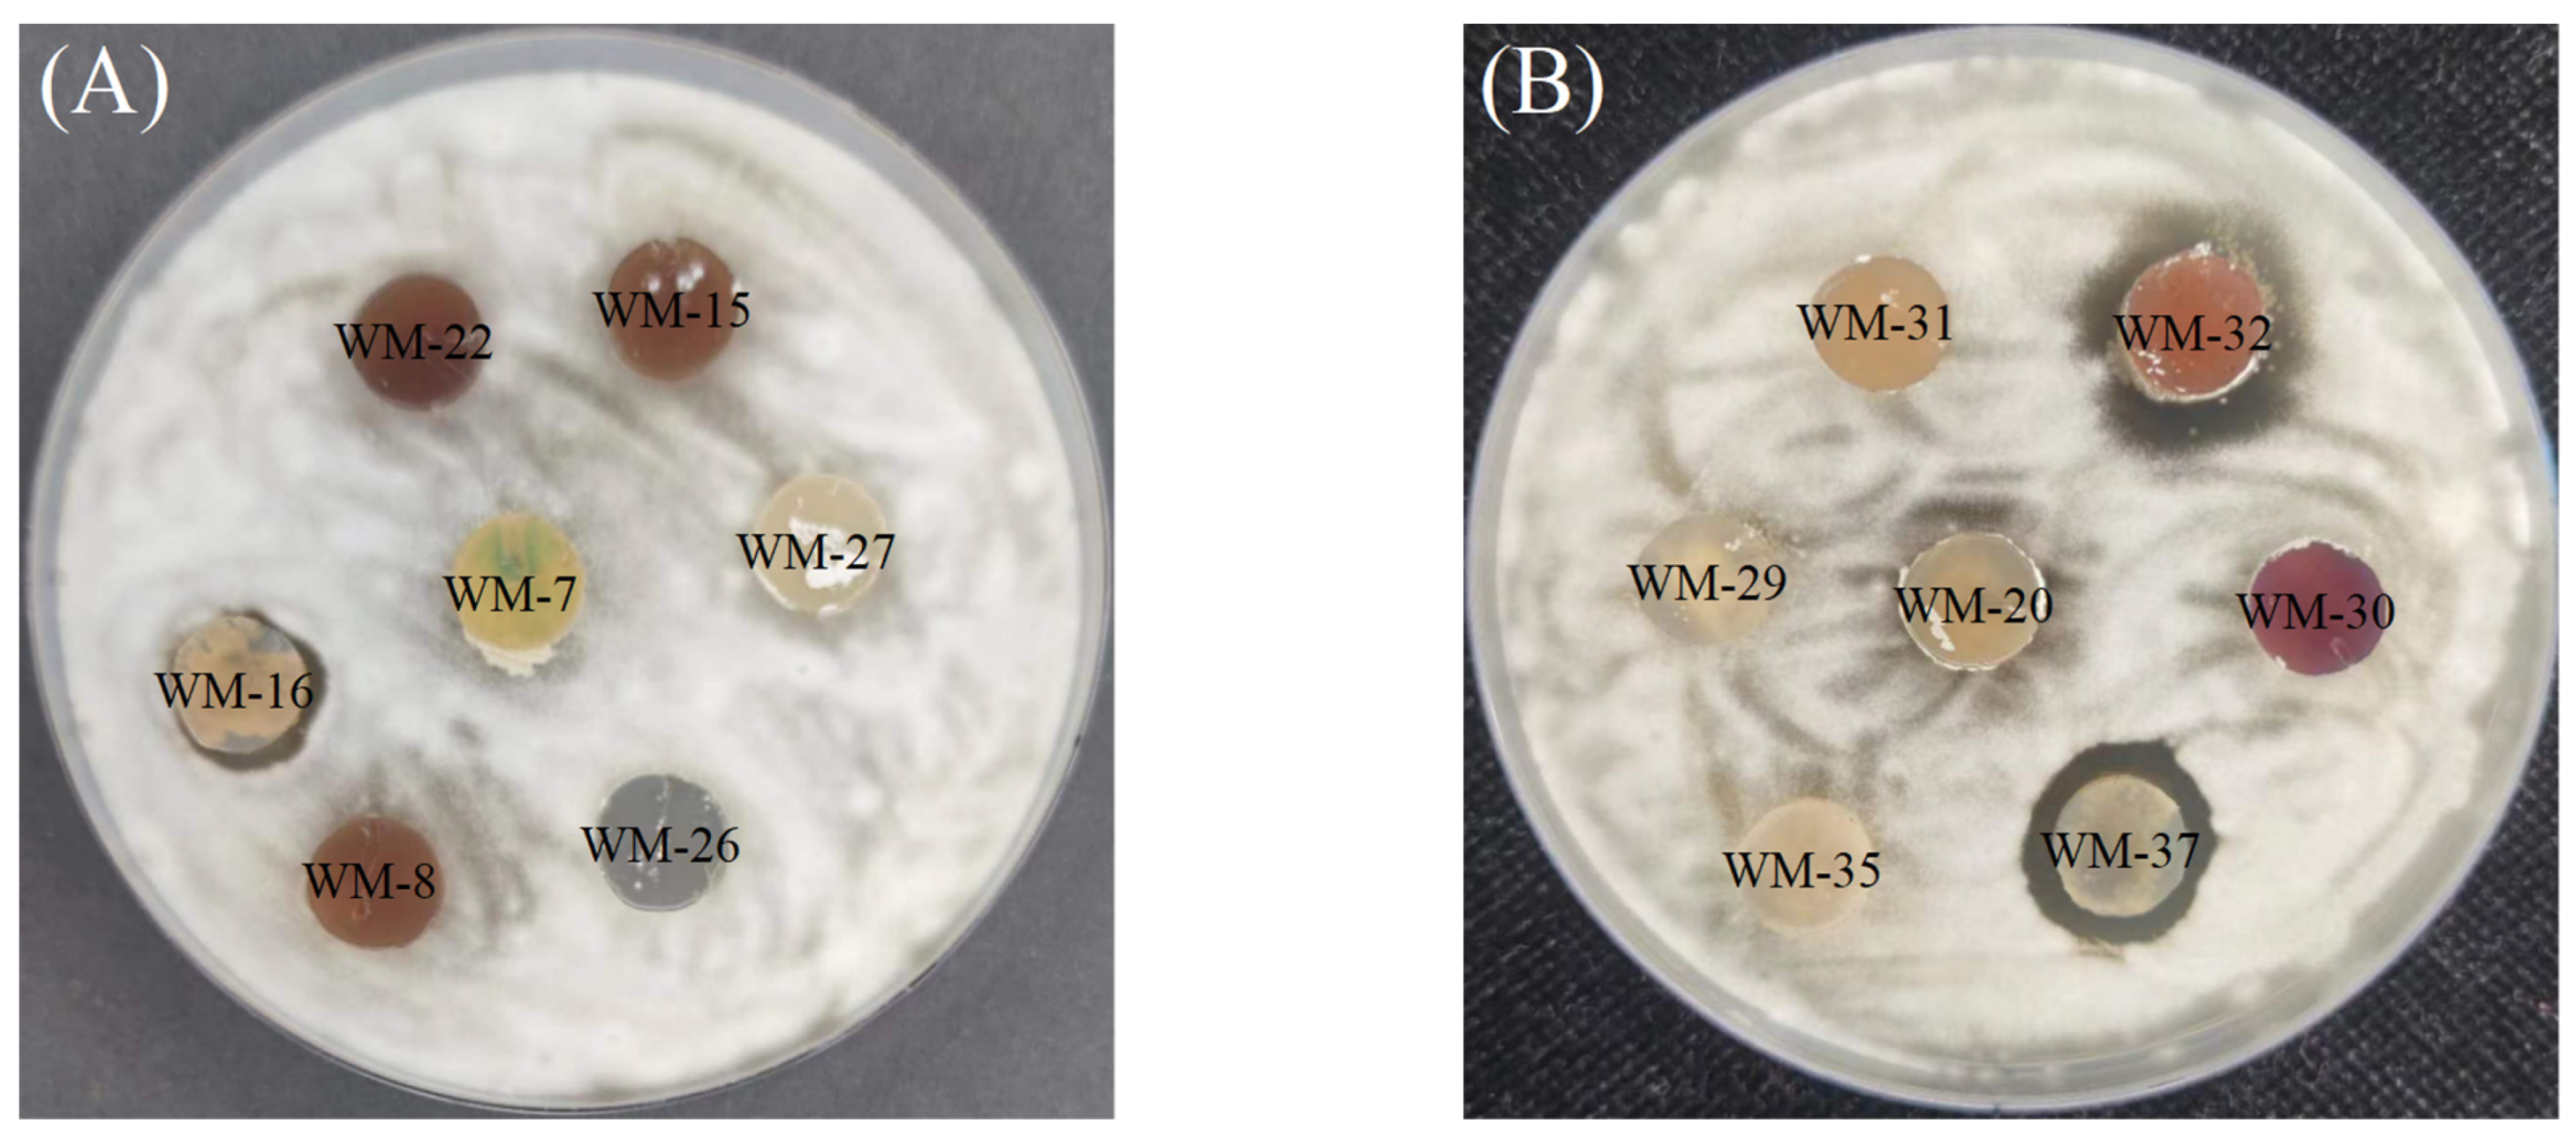
Agriculture 14 00833 g001
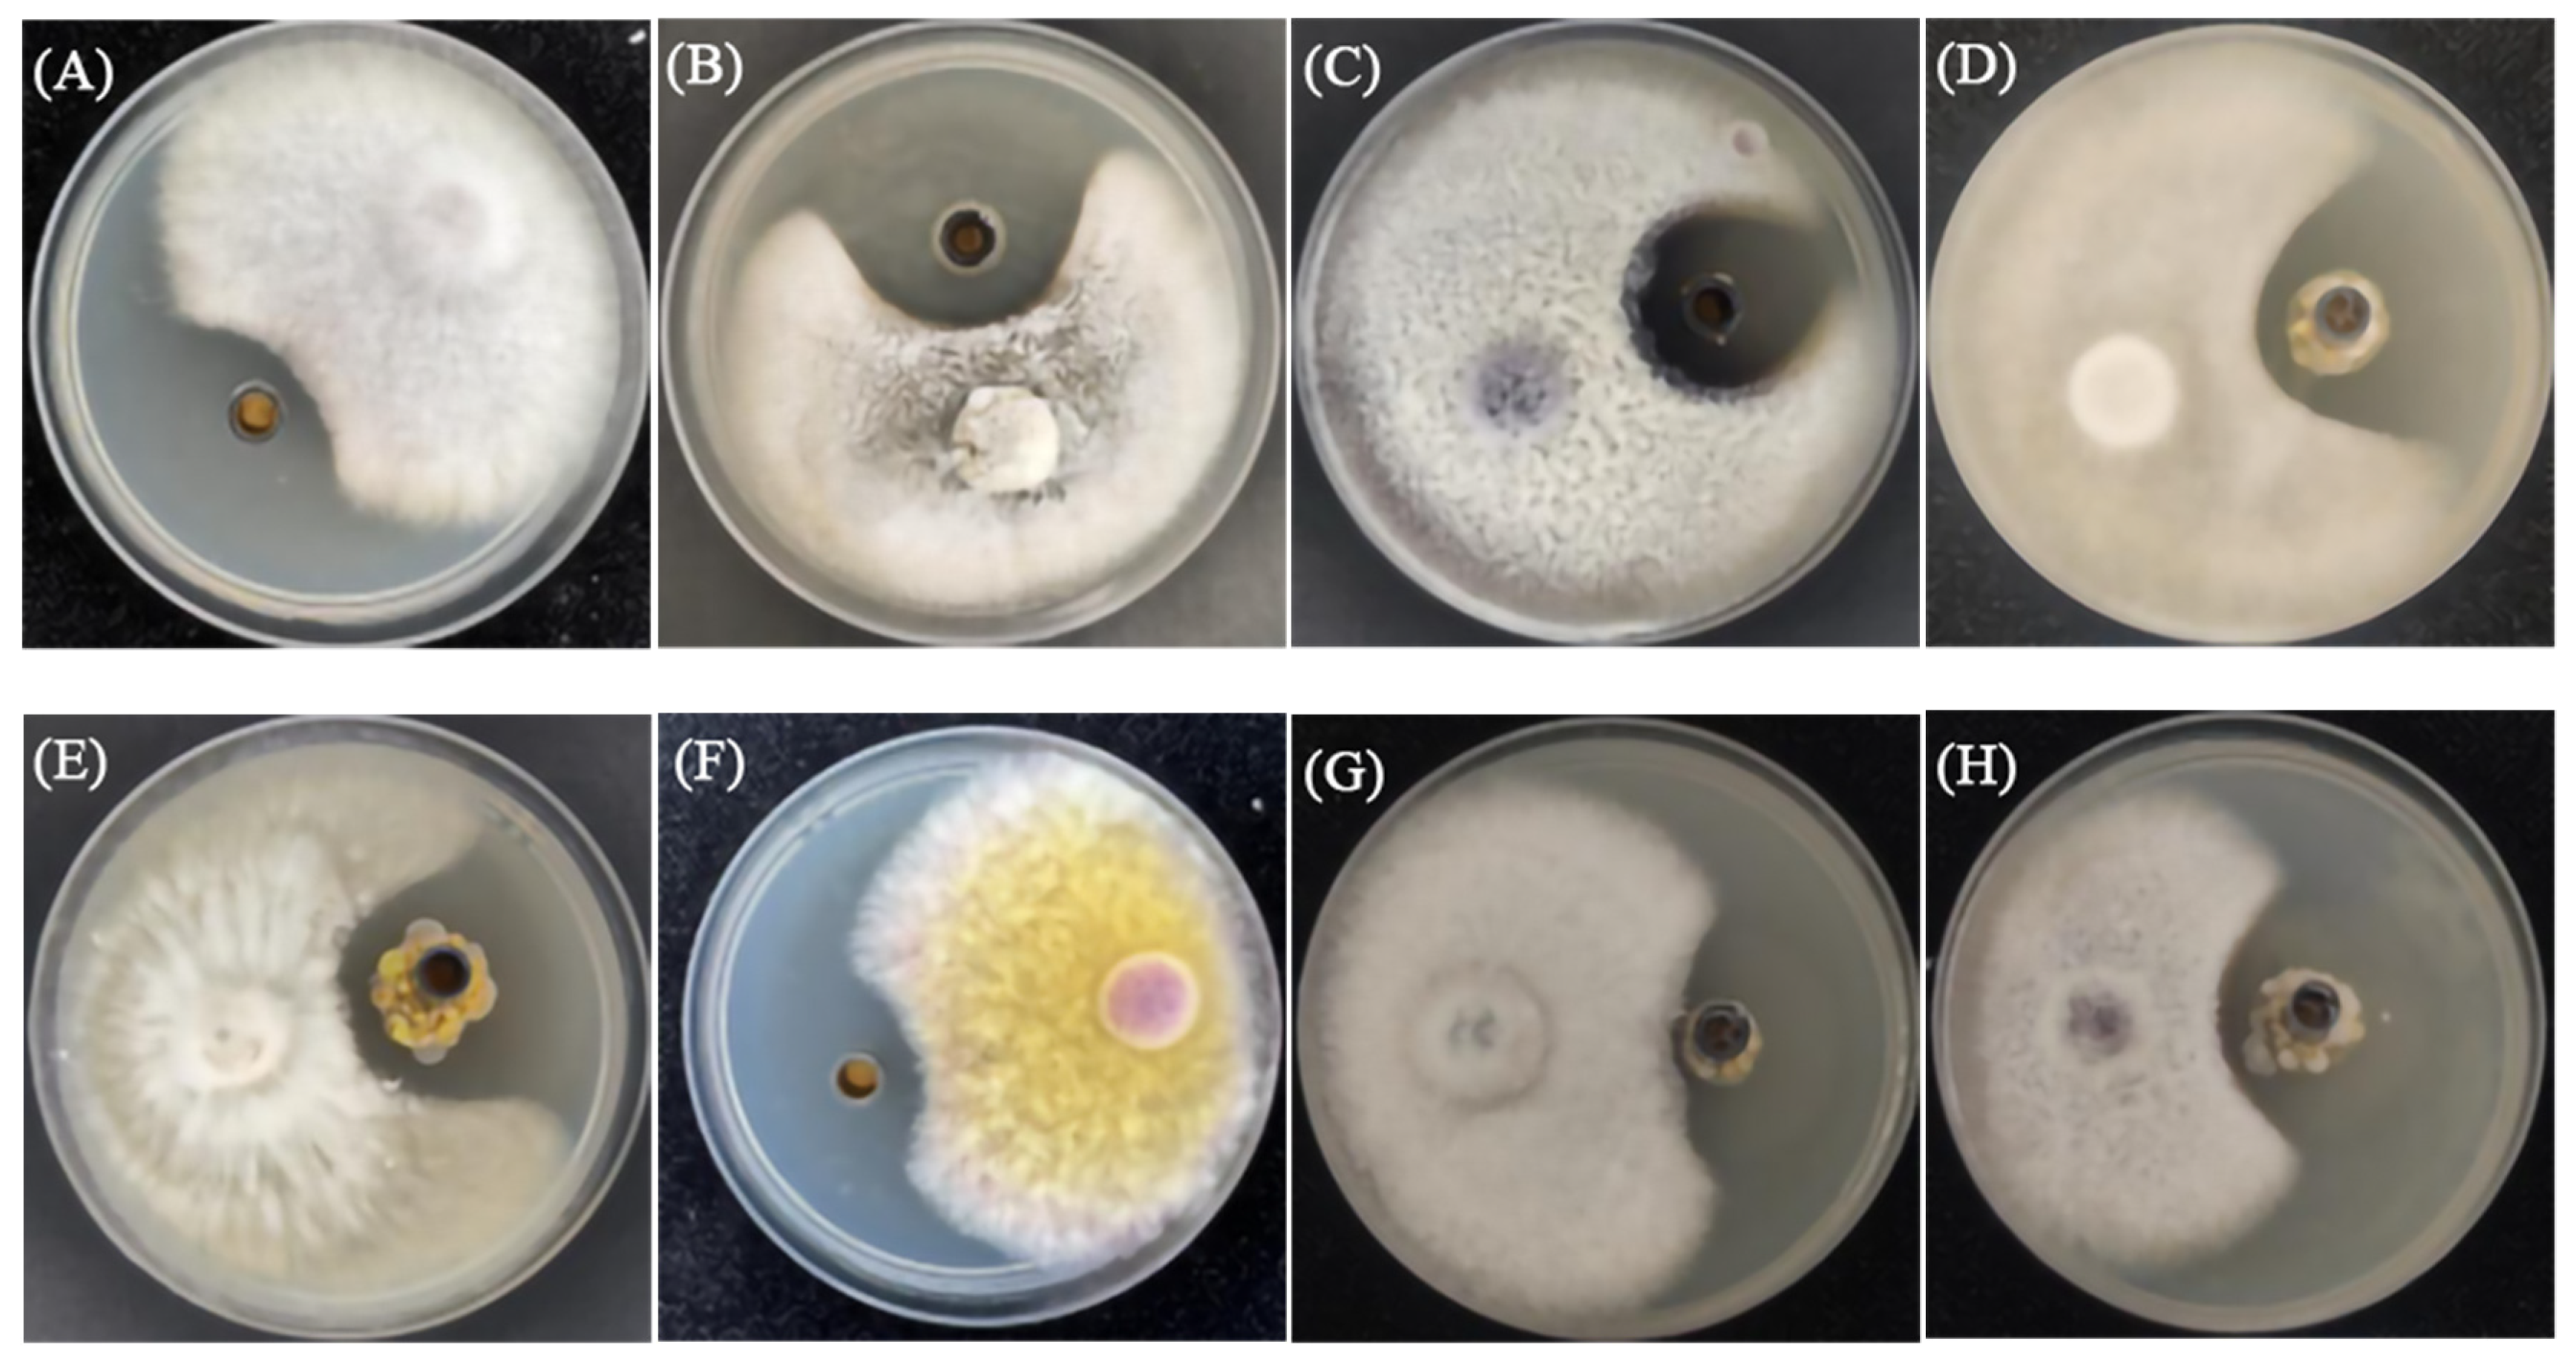
Agriculture 14 00833 g003

3.3. Fermentation Conditions
- (1)
Effect of carbon sources on the inhibitory activity of S. rectiviolaceus
Trials involving the addition of soluble starch, maltose, sucrose, galactose, and glucose to the fermentation medium showed that supernatant samples of fermentation broth based on all these carbon sources inhibited pathogenic fungal growth. The rank-order of inhibition zone diameters for the tested carbon sources (largest to smallest) was as follows: soluble starch > sucrose > galactose > maltose > glucose. Notably, soluble starch had the strongest effect, which was consistent with the findings of an earlier study that determined soluble starch was the optimal carbon source for the fermentation of
Streptomyces rochei [
35]. There was a statistically significant difference (
p < 0.05) between the effect of soluble starch (inhibition zone diameter of 16.68 ± 0.27 mm) and the effects of the other four carbon sources (
Figure 6). Thus, soluble starch was selected as the optimal carbon source. The inhibition zone diameter increased as the soluble starch concentration increased from 10.0 to 20.0 g·L
−1, but further increases in the soluble starch concentration (up to 30.0 g·L
−1) decreased the inhibition zone diameter (
Figure 7). Accordingly, the optimal soluble starch concentration was determined to be 20.0 g·L
−1.
- (2)
Effect of nitrogen sources on the inhibitory activity of S. rectiviolaceus
When potassium nitrate, ammonium sulfate, yeast extract, peptone, and ammonium nitrate were added to the fermentation medium, the addition of all the nitrogen sources resulted in inhibitory effects on pathogenic fungal growth. The rank-order of inhibition zone diameters for the examined nitrogen sources (largest to smallest) was as follows: ammonium sulfate > potassium nitrate > ammonium nitrate > peptone > yeast extract. Notably, among these nitrogen sources, ammonium sulfate had the strongest effect, which was in accordance with the previously reported optimal nitrogen source for the fermentation of
Streptomyces JD211 [
36]. There were significant differences (
p < 0.05) between the effect of ammonium sulfate (inhibition zone diameter of 18.97 ± 0.18 mm) and the effects of three other nitrogen sources (
Figure 8). Hence, ammonium sulfate was selected as the optimal nitrogen source. Moreover, the inhibition zone diameter increased as the ammonium sulfate concentration increased from 1.0 to 4.0 g·L
−1, but further increases in the ammonium sulfate concentration (up to 5.0 g·L
−1) decreased the inhibition zone diameter (
Figure 9). Ultimately, the optimal ammonium sulfate concentration was determined to be 4.0 g·L
−1.
- (3)
Effect of inoculation amount on the inhibitory activity of S. rectiviolaceus
Of the tested inoculation amount (4%, 6%, 8%, 10%, and 12%), 8% inoculum resulted in the fermentation broth with the strongest inhibitory effect. The effect of this inoculation amount (inhibition zone diameter of 16.86 ± 0.28 mm) differed significantly (
p < 0.05) from the effects of two other inoculation amounts (
Figure 10). Thus, an 8% inoculum was considered to be the optimal inoculation amount.
- (4)
Effect of temperature on the inhibitory activity of S. rectiviolaceus
Analyses of the effects of various temperatures (26, 28, 30, 32, and 34 °C) indicated that the inhibition zone diameter initially increased and then decreased as the temperature increased. The antifungal activity of the fermentation broth peaked at 30 °C, with an inhibition zone diameter (16.81 ± 0.16 mm) that was significantly larger (
p < 0.05) than the inhibition zone diameters for three other temperatures (
Figure 11). Hence, 30 °C was selected as the optimal temperature.
- (5)
Effect of initial pH on the inhibitory activity of S. rectiviolaceus
Fermentation broth activity initially increased and then decreased as the initial pH increased (6, 6.5, 7, 7.5, and 8), with peak activity at initial pH 7.0 (inhibition zone diameter of 16.81 ± 0.52 mm). The effect of initial pH 7.0 was significantly different (
p < 0.05) from the effects of three other initial pH levels (
Figure 12). Therefore, initial pH 7.0 was selected as the optimal initial pH.
- (6)
Effect of incubation time on the inhibitory activity of S. rectiviolaceus
Fermentation broth activity initially increased significantly (
p < 0.05) as the incubation time increased, reaching peak levels at 7 days (inhibition zone diameter of 16.50 ± 0.40 mm). The observed activity was not significantly affected by further increases in the incubation time (8 and 9 days) (
Figure 13). Hence, 7 days was selected as the optimal incubation time.
- (7)
Effect of rotational speed on the inhibitory activity of S. rectiviolaceus
A trial was conducted to assess the effects of different rotational speeds (120, 140, 160, 180, and 200 rpm). As the rotational speed increased, the fermentation broth activity initially increased and then decreased (
Figure 14). The antifungal activity was highest at a rotational speed of 160 rpm, with an inhibition zone diameter of 16.89 ± 0.15 mm. The effect of 160 rpm differed significantly (
p < 0.05) from the effects of three other rotational speeds. Accordingly, 160 rpm was selected as the optimal rotational speed.
- (8)
Placket–Burman test results
After considering the fundamental nutrient components required for microbial growth and the results of the single-factor trials, soluble starch (
X1), ammonium sulfate (
X2), inoculation amount (
X3), temperature (
X4), initial pH (
X5), incubation time (
X6), and rotational speed (
X7) were selected for error analyses. Each variable had two levels (−1 and +1). There were a total of seven factors and 12 trial groups, and three replicates were performed in each group. The factors and their levels are summarized in
Table 2.
The Placket–Burman trial data are presented in
Table 3. By analyzing the main effects and the significance of each factor (
Appendix A,
Table A1), ammonium sulfate concentration, inoculation amount, and incubation time were revealed as the three most significant factors affecting liquid fermentation. All three factors significantly affected fermentation (
p < 0.05). Other factors have little effect on fermentation (
p > 0.05). The regression model was statistically meaningful.
- (9)
Results of the steepest ascent trial
The Plackett–Burman test indicated that among the factors influencing the conditions for the fermentation of WM-37, the ammonium sulfate concentration, inoculation amount, and incubation time significantly influenced the inhibition zone diameter (Y value). All three of these factors had significant positive effects. The direction and step size of these three factors should be determined according to their proportional impact. Trial condition 3 was optimal (
Table 4), resulting in an inhibition zone diameter of 21.85 ± 0.49 mm. Therefore, it was selected for the trials involving individual factors.
- (10)
Box–Behnken trial results
To determine the interactions among
X2,
X3, and
X6, a Box–Behnken design was employed to analyze 17 trial groups. The factors and their levels are summarized in
Table 5. The trial design and results are presented in
Table 6.
On the basis of the trial data, a quadratic polynomial regression analysis was performed to predict the key factors associated with the maximum inhibition zone diameter. As shown in
Appendix A,
Table A2, the model had a highly significant value (
p < 0.0001), whereas the lack of fit was 0.5444 (insignificant), indicating that the model was reliable and could be used for subsequent optimization and prediction work. The
R2 value of the regression equation was 0.9869, whereas the adjusted
R2 value was 0.9701 (i.e., both exceeded 0.8). The difference between
R2Adj (0.9701) and
R2Pre (0.9074) was less than 0.2, indicating the model was highly significant. Thus, the Box–Behnken model was reliable and accurate. Design-Expert 13 software was used to process the data, which resulted in the following regression equation: 21.70 − 0.6487
X2 − 0.2775
X3 + 0.3213
X6 + 0.9225
X2X3 + 1.01
X2X6 + 0.0625
X3X6 − 1.60
X22 − 1.02
X32 − 2.00
X62. As shown in
Figure 15 and
Figure 16, when the concentration of ammonium sulfate was constant, the inoculation amount increased from 7% to 9%, and the incubation time increased from 6.5 days to 7.5 days, the inhibitory diameter showed a trend of first increasing and then decreasing. As shown in
Figure 15 and
Figure 17, when the inoculation amount was constant, the concentration of ammonium sulfate increased from 3.5 g·L
−1 to 4.5 g·L
−1, and the incubation time increased from 6.5 days to 7.5 days, the inhibitory diameter showed a trend of first increasing and then decreasing. As shown in
Figure 16 and
Figure 17, when the incubation time was fixed, the concentration of ammonium sulfate increased from 3.5 g·L
−1 to 4.5 g·L
−1, and the inoculated amount increased from 7% to 9%, the inhibitory diameter showed a trend of first increasing and then decreasing. The response surface analysis diagram and surface diagram of the above results were convex, indicating that the inhibitory diameter has a maximum value. After Design-Expert 13 software was used to process the regression equation, the predicted optimal conditions (3.86 g·L
−1 ammonium sulfate; 7.74% inoculation amount; and 7-day incubation time) were expected to result in an inhibition zone diameter of 21.83 mm. In summary, the basic fermentation medium composition and conditions were as follows: erlenmeyer flask of 250 mL, liquid volume of 100mL, soluble starch of 20.0 g·L
−1, potassium nitrate of 1.0 g·L
−1, sodium chloride of 0.5 g·L
−1, dipotassium phosphate of 0.5 g·L
−1, magnesium sulfate of 0.50 g·L
−1, ferrous sulfate of 0.01 g·L
−1, inoculation amount of 8%, temperature of 30 °C, initial pH of 7.0, incubation time of 7-day, and rotation speed of 160 rpm. The optimized fermentation medium composition and conditions were as follows: erlenmeyer flask of 250 mL, liquid volume of 100 mL, soluble starch of 20.0 g·L
−1, ammonium sulfate of 3.86 g·L
−1, sodium chloride of 0.5 g·L
−1, dipotassium phosphate of 0.5 g·L
−1, magnesium sulfate of 0.50 g·L
−1, ferrous sulfate of 0.01 g·L
−1, inoculation amount of 7.74%, temperature of 30 °C, initial pH of 7.0, incubation time of 7-day, and rotation speed of 160 rpm.
- (11)
Model validation trial
The optimal fermentation conditions predicted using the response surface method (i.e., 3.86 g·L−1 ammonium sulfate; 7.74% inoculation amount; and 7-day incubation time) resulted in an inhibition zone diameter of 21.56 ± 0.32 mm (i.e., 98.76% of the predicted diameter). Thus, the model accurately predicted the optimal fermentation conditions.